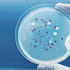
Yeni bir antibiyotik familyası keşfedildi

MORE IN TEHNOLOJI»

Cedi Osman galibiyete katkı sağladığı için mutlu
14 Şubat 2018 20:56
İstanbul'da gökkuşağı sürprizi
14 Şubat 2018 18:59
İYİ Partililerden şehitliğe 'Sevgili Mehmetçik' ziyareti
14 Şubat 2018 18:59
Ergene Velimeşe Spor - Diyarbekir Spor: 2-1
14 Şubat 2018 18:59
Bakan Özlü, yarın İzmir'de
14 Şubat 2018 15:57 resimsiz950 kilogram amonyum nitrat maddesi ele geçirildi
14 Şubat 2018 18:59 resimsizKuzey Kore'nin Olimpiyat masraflarını Güney Kore ödeyecek
14 Şubat 2018 18:59
Özel halk otobüsünde cinsel tacize tutuklama
14 Şubat 2018 18:59 resimsizFransız Bakan Darmanin'e yeni taciz suçlaması
14 Şubat 2018 18:59
Bursa Büyükşehir Belediyespor - İlbank: 3-0
14 Şubat 2018 18:59 resimsizİcra ve İflas Kanunu Adalet Komisyonunda kabul edildi
14 Şubat 2018 18:59 resimsizTaraftardan Samsunspor’a 'sevgi' gösterisi
14 Şubat 2018 18:59 resimsizKazdıkları toprağın altında kalan baba ve oğlu öldü
14 Şubat 2018 18:59
Ortaokul öğrencilerinden Mehmetçik'e destek
14 Şubat 2018 18:59 resimsizBolu'da ıza buğdayının üretimi yaygınlaştırılacak
14 Şubat 2018 18:59
Teknik lise ve klinik atölyesi için protokol imzalandı
14 Şubat 2018 18:59 resimsizTrabzonspor’da Burak Yılmaz takımla çalışmalara başladı
14 Şubat 2018 18:59
Bülent Tezcan: Bu hükümet şehitleri icra takibine maruz kalacak …
14 Şubat 2018 18:59
Altının kilogramı 162 bin 500 liraya yükseldi
14 Şubat 2018 18:59
Beşiktaş, Atiker Konyaspor'a bileniyor
14 Şubat 2018 18:59
Cumhurbaşkanı Erdoğan, Gambiya Cumhurbaşkanı Barrow'u resmi töre…
14 Şubat 2018 18:59
Ocak ayında 1.8 milyar liralık çek karşılıksız çıktı
14 Şubat 2018 17:55
SpaceX internet uyduları fırlatmaya hazır
14 Şubat 2018 17:49
Yeni nesil hibrit soğan üretildi
14 Şubat 2018 16:49
FBI, CIA ve NSA Çinli telefon markalarına savaş açtı
14 Şubat 2018 15:47 resimsizMustafa Cengiz: Dursun Özbek'ten alacağımız var
14 Şubat 2018 14:56
Milli uydumuz RASAT Yunanistan'ı uzaydan görüntüledi
14 Şubat 2018 14:51
Yeni bir antibiyotik familyası keşfedildi
14 Şubat 2018 14:50
Yerli baz istasyonu ULAK saha testinden geçti
14 Şubat 2018 13:48
Türk Hava Kuvvetleri'ne iki yeni A400M daha
14 Şubat 2018 12:46 resimsizBorussia Dortmund-Atalanta maçı ne zaman, saat kaçta, hangi kana…
14 Şubat 2018 12:00 resimsizAtatürk Havalimanı'ndan kürk operasyonu
14 Şubat 2018 12:00
Subaşı Belediye Başkanı Yılmaz: Amacımız beldemizi her yönüyle k…
14 Şubat 2018 12:00 resimsizGuardian'dan çarpıcı Beşiktaş analizi (Son dakika Beşiktaş haber…
14 Şubat 2018 12:00
(Ek bilgi ve fotoğraflarla) - Vasat Cemaati lideri Şahmerdan Sar…
14 Şubat 2018 12:00
Evden kaçan gençler yol kontrolünde yakalandı
14 Şubat 2018 12:00
Facebook’a 'Listeler' özelliği geliyor
14 Şubat 2018 11:49
Warface tutkunlarına müjde
14 Şubat 2018 11:45
'Robotlar, geleceğin kalaşnikofları olabilir'
14 Şubat 2018 11:03 resimsizAstana-Sporting Lizbon maçı ne zaman, saat kaçta, hangi kanalda?
14 Şubat 2018 10:59 resimsizDağa kazdıkları tünellerden sızmaya çalışan 13 YPG'li öldürüldü
14 Şubat 2018 10:59
SSM, Kıyıya Çıkış Simülatörü Projesi başlatıyor
14 Şubat 2018 10:50
Nefertiti’nin yüzü yeniden modellendi
14 Şubat 2018 09:47
Alman mahkemesi: Facebook kanunlara aykırı davranıyor
14 Şubat 2018 09:45
Yapay zeka, Dünya’yı asteroidlerden korumakta kullanılacak
14 Şubat 2018 08:50 resimsizAfrin şehidinin annesiyle son konuşması: Korkma anne, silah sesi…
14 Şubat 2018 06:50HOTTEST NEWS IN TEHNOLOJI»
WHAT'S NEW IN TEHNOLOJI»
- Instagram'da mesajları 'görüldü' yapmadan ok…
- NASA, Ay programına 93 milyar dolar harcayac…
- 'Yemeksepeti hack'lendi 50 milyon kullanıcın…
- Internet Explorer, kullanıcıların başına bel…
- Windows'ta ekran kartı sıcaklığını öğrenmeni…
- Rusya havaya uçurdu! ABD ve NASA ayağa kalkt…
- Son teknoloji! Mehmetçik, teröristleri yerli…
- Twitter, zincir gönderileri birleştiren Thre…
- NVIDIA'nın 40 milyar dolara ARM'yi satın alm…
- Tunceli'de teröristlerin kullandığı 2 sığına…
- Ali Atay ve oğlu Fikret Ali'nin neşeli halle…
- Bakan Dönmez: Maden ihracatımız 4,38 milyar …
- WhatsApp'ta yeni dolandırıcılık yöntemi: Yak…
- Dünyanın en büyük elmas madeninde heyecanlan…
- Doğumda yeni bir ıkınma tekniği buldular
- Battlefield 2042 sistem gereksinimleri, çıkı…
- Tesla, Starlink internetini şarj istasyonlar…
- Siber saldırganlar, 2022 FIFA Dünya Kupası'n…
- Google'ın katlanabilir telefonu Google Pixel…
- Askerin güven kalkanı milli teknoloji! Sınır…


